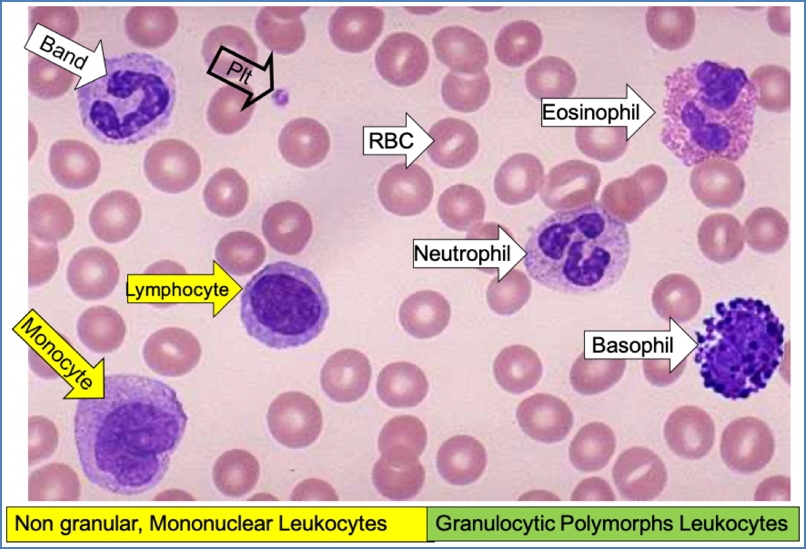
System for Looking at Blood Smears

Table of Contents
Overview – Haematopoiesis
Haematopoiesis (also spelled hematopoiesis) refers to the formation of blood cells from pluripotent stem cells, a critical process that ensures constant renewal and replenishment of the blood’s cellular components. It occurs primarily in the bone marrow postnatally and dynamically responds to physiological demands such as infection, anaemia, or hypoxia. Understanding haematopoiesis is essential for recognising blood disorders, interpreting full blood counts, and understanding the pathogenesis of haematological malignancies.
Definition
- Haematopoiesis = production of all blood cell types from pluripotent stem cells
- Required due to:
- Constant turnover and destruction of blood cells
- Need for rapid upregulation in response to physiological stress (e.g. infection, hypoxia)
Sites of Haematopoiesis
Foetal Life
- Yolk sac (1st trimester)
- Liver & spleen (main sites during mid-gestation)
- Bone marrow (starts late in gestation)
Postnatal Life
- Bone marrow becomes the primary site
- Extramedullary haematopoiesis (liver, spleen) can reactivate in severe disease states

Cell Lineages
Haematopoietic Stem Cells
- Pluripotent and self-renewing
- Can differentiate into two major progenitor lines:
- Myeloid stem cells
- Erythroid lineage: Proerythroblast → Reticulocyte → RBCs
- Granulocyte lineage:
- Myeloblasts → Neutrophils
- Eosinophilic myeloblasts → Eosinophils
- Basophilic myeloblasts → Basophils
- Monocyte lineage: Monoblast → Monocytes → Macrophages
- Megakaryocyte lineage: Megakaryoblasts → Megakaryocytes → Platelets
- Lymphoid stem cells
- B-lymphoblasts → B-cells
- T-lymphoblasts → T-cells
- NK cells
- Myeloid stem cells
- Significant amplification: 1 stem cell → 10 million blood cells after ~20 divisions

Haematopoietic Growth Factors
- Regulate differentiation, survival, maturation, and function of blood cells
- Examples include:
- Interleukins (ILs)
- Colony Stimulating Factors (CSFs)
- Thrombopoietin (TPO) – platelet production
- Erythropoietin (EPO) – red cell production
- Functions:
- Promote specific lineage development
- Stimulate maturation
- Inhibit apoptosis
- Modulate function of mature immune cells

Clinical Relevance
Haematological Malignancies
- Leukaemias and lymphomas may arise from clonal defects in haematopoietic stem or progenitor cells
- May require:
- Chemotherapy or total body irradiation
- Haematopoietic stem cell transplantation
Blood Smear Interpretation
Normal Appearance
- RBCs: Round, central pallor, ~size of a small lymphocyte
- WBCs:
- Neutrophils
- Eosinophils
- Basophils
- Monocytes
- Lymphocytes
- Platelets: Small, anuclear cell fragments

Systematic Approach
- RBCs – size, colour, shape
- WBCs – count and type
- Platelets – number, size, distribution
- Abnormalities – parasites, blasts, schistocytes, sickle cells
White Cell Abnormalities
| Cell Type | Causes of -Philias | Causes of –Penias |
|---|---|---|
| Neutrophils | Infection, inflammation, infarction, malignancy, steroids | Viral infections, autoimmune, drugs, alcohol, congenital (e.g. Kostmann’s) |
| Eosinophils | Allergy, parasitic infection, skin/connective tissue diseases | Acute inflammation, corticosteroids |
| Basophils | Myeloproliferative disorders, inflammation, iron deficiency | Hyperthyroidism |
| Monocytes | TB, connective tissue diseases, malignancy | Rarely low in isolation |
| Lymphocytes | Viral infections, pertussis, lymphoproliferative disease | Steroids, cytotoxics, SCID, renal failure |
Summary – Haematopoiesis
Haematopoiesis is the lifelong process of blood cell production, starting in the yolk sac during foetal life and transitioning to the bone marrow postnatally. It ensures the continuous renewal of red cells, white cells, and platelets and adapts dynamically to physiological needs. Disruptions in this system underpin a wide range of clinical conditions, including leukaemias and cytopenias. For a broader context, see our Blood & Haematology Overview page.